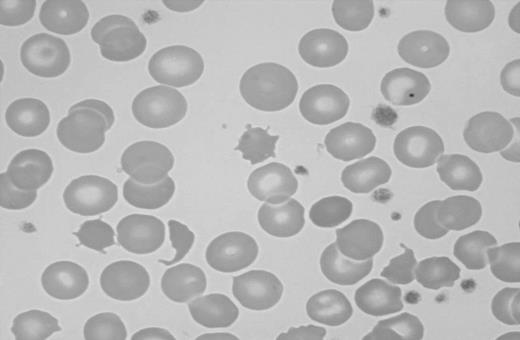
Figure 2. Blood smear showing characteristic findings of hyposplenism such as Howell-Jolly bodies, acanthocytes, and target cells. Image was observed using an Olympus Provis AX70 microscope equipped with an Olympus PlanApo 60 ×/1.40 numerical aperture oil objective (Olympus, Tokyo, Japan). Resolve high-viscosity immersion oil was used as imaging medium, and cells were stained with Wright-Giemsa. Image was acquired using a Nikon DXM 1200 digital camera and Nikon ACT-1 software version 2.62 (Nikon, Melville, NY).

Abstract
Celiac disease is a common systemic disorder that can have multiple hematologic manifestations. Patients with celiac disease may present to hematologists for evaluation of various hematologic problems prior to receiving a diagnosis of celiac disease. Anemia secondary to malabsorption of iron, folic acid, and/or vitamin B12 is a common complication of celiac disease and many patients have anemia at the time of diagnosis. Celiac disease may also be associated with thrombocytosis, thrombocytopenia, leukopenia, venous thromboembolism, hyposplenism, and IgA deficiency. Patients with celiac disease are at increased risk of being diagnosed with lymphoma, especially of the T-cell type. The risk is highest for enteropathy-type T-cell lymphoma (ETL) and B-cell lymphoma of the gut, but extraintestinal lymphomas can also be seen. ETL is an aggressive disease with poor prognosis, but strict adherence to a gluten-free diet may prevent its occurrence.
Introduction
Celiac disease (CD), or gluten-sensitive enteropathy, is a systemic disorder with protean manifestations. It is a common disease, previously described mainly in children but is now increasingly being diagnosed in persons of all ages.1 In the past, CD was usually considered only in patients who had frank malabsorption characterized by diarrhea, steatorrhea, weight loss, or failure to thrive or in the patient with multiple deficiencies of macronutrients and micronutrients. This could be termed the classic form. It has become clear that many, if not most, patients can present with much more subtle symptoms, often called atypical celiac disease, and often without the classic malabsorption syndrome or even diarrhea. Some, if not many, patients may have silent celiac disease wherein they have no symptoms at all. Dermatitis herpetiformis (DH) is an intensely pruritic immunologic skin disorder that is characterized by gluten sensitivity and, like CD, it responds to withdrawal of gluten from the diet.2
While CD has been considered a relatively rare disease, recent population-screening studies have suggested that it may affect as much as 1% of the population.3-6 The purpose of this review is to summarize the associations of CD with both common and uncommon conditions that may be of interest to hematologists and internists and to provide guidance as to the appropriate means of investigation to aid in identifying CD in a timely fashion.
CD is a common cause of various hematologic disorders, the most common of which is anemia. The anemia of CD is usually due to malabsorption of micronutrients such as iron, folic acid, and vitamin B12. CD is also frequently implicated in the etiology of other blood-count abnormalities, splenic hypofunction, and intestinal lymphomas.7 The hematologic manifestations of DH are less well described but DH has been associated with anemia and splenic dysfunction, and patients with DH have been found to be at increased risk of contracting malignant lymphoma. Additionally, some of the drugs used in the treatment of DH (primarily dapsone) have been associated with side effects such as hemolysis and methemoglobinemia. The hematologic manifestations of CD are summarized in Table 1.
Diagnosis of celiac disease
The diagnosis of CD is usually made with the aid of a small-bowel biopsy. Pathologic diagnosis based on finding villous atrophy of the small-bowel mucosa is still considered the gold standard of diagnosis.8,9 Serologic testing is based on identifying IgA antibodies against gliadin, endomysium, and tissue transglutaminase. Antigliadin antibodies are less used due to their low sensitivity and specificity.10 A recent systematic review of the diagnostic accuracy of the various available antibody assays revealed that the sensitivity of antiendomysial antibodies (anti-EMAs) and anti–tissue-transglutaminase (anti-tTG) antibodies is more than 90%.11 The pooled sensitivity of the anti-EMA was between 90% and 97%, and anti-tTG antibodies had a pooled sensitivity of 90% to 98%, depending on the methods used and the population studied. Anti-tTG antibodies are the most practical test and is now widely used for diagnosing CD. The co-occurrence of IgA deficiency in 3% to 5% of CD patients poses certain difficulties in using serologic methods for diagnosis. Thus it may be appropriate to measure total IgA levels before concluding that negative serologic tests have excluded CD. Serologic testing using IgG-type anti-tTG antibodies appears to be helpful in diagnosing CD patients with concomitant IgA deficiency.12 A practical diagnostic algorithm is depicted in Figure 1. Patients with a high risk of having CD, such as those with the malabsorption syndrome, should have both serologic tests and an upper endoscopy with intestinal biopsy performed. Patients with a lower risk of having CD, such as patients with anemia only or anemia associated with other subtle features of CD (such as infertility, diarrhea, or type 1 diabetes), may be evaluated with serologic tests initially, followed by intestinal biopsy if the serology is positive.
Anemia
Anemia is a frequent finding in patients with CD and may be the presenting feature.13,14 The anemia may be the only abnormality identified.14,15 Anemia was particularly common in patients with untreated CD in the past but is still frequently encountered in undiagnosed adults.15,16 The anemia is usually hypoproliferative, reflecting impaired absorption of essential nutrients like iron and various vitamins. The prevalence of anemia varies greatly according to different reports and has been found in 12% to 69% of newly diagnosed patients with CD.14-18 DH has also been associated with anemia that can be secondary to malabsorption of iron or vitamins or related to the pharmacologic management of DH, especially therapy with dapsone.19,20
Iron-deficiency anemia
Iron-deficiency anemia (IDA) is the most commonly encountered anemia in humans and is usually due to either increased iron loss or impaired absorption of iron.21 IDA is very common in the setting of CD and has been reported in up to 46% of cases of subclinical CD, with a higher prevalence in adults than children.15 Iron deficiency has also been reported in patients with DH.22,23 Iron is absorbed in the proximal small intestine and the absorption is dependent upon several factors, including an intact mucosal surface and intestinal acidity.21 IDA usually manifests as microcytic, hypochromic anemia and patients characteristically have low serum iron levels, elevated total iron-binding capacity, and low ferritin levels.24 Measurements of soluble transferrin receptors (sTfRs) can also be valuable in the evaluation of IDA, and the ratio of sTfR to ferritin may indicate CD in children with refractory IDA.25,26 Iron deficiency that is refractory to therapy can be the sole manifestation of CD, especially in pediatric patients.27-29 The prevalence of CD in patients with refractory IDA may be as high as 20%.30
The iron deficiency in celiac disease primarily results from impaired absorption of iron but there may also be occult blood loss in the gastrointestinal (GI) tract.31,32 Occult gastrointestinal bleeding was detected in 25% to 54% of patients with CD, depending on the degree of villous atrophy, in 1 study.33 Occult GI blood loss was seen in 26.7% of children with CD and appears to respond to treatment with a gluten-free diet GFD, according to another study.34 More-recent studies have, however, suggested that occult GI bleeding in patients with CD may be much less common.35,36
CD is frequently diagnosed in patients referred for evaluation of anemia, and subclinical CD appears to be a relatively common cause of IDA.15,37-39 Studies using serologic tests and small-bowel biopsies in patients referred for evaluation of IDA have reported CD in 0% to 8.7% of patients (Table 2)37-46 These studies are heterogeneous in design and used different methods for diagnosis of CD, often in selected referral populations.
Two studies evaluated only patients with IDA and 1 of them did not use serologic testing. Biopsy-proven CD was reported in 2.6% to 5% of patients.37,42 Three other studies included patients with anemia other than IDA but the vast majority in all 3 studies suffered from IDA.39,43,44 Serologic evidence of CD was observed in 2.3% to 10.9% of these anemic patients. In 2 of the studies, biopsies were performed on the patients with positive serology, and the prevalence of biopsy-proven CD was 2.3% to 4.7%.39,44
Four studies evaluated the role of upper endoscopy in the evaluation of iron deficiency (Table 2).40,41,45,46 In only 1 of these studies were biopsies performed on all patients evaluated, and 8.7% of patients were found to have CD.45 The other 3 studies showed lower prevalence of CD in patients with IDA, ranging from 0% to 5.7%.40,41,46 One of the studies suggested that history of chronic diarrhea predicted CD as the cause for the anemia.46 Clinicians should consider CD as a possible cause of anemia in all subjects with unexplained IDA, including menstruating women.
Endoscopic markers of CD in patients with IDA have been shown to lack sensitivity for diagnosis and have limited utility in selecting patients for a small-bowel biopsy.47 Duodenal biopsies should be performed even if the duodenal mucosa appears normal to the endoscopist. One recent study has shown that many patients undergoing an endoscopy for anemia do in fact not have a small-bowel biopsy performed.48
In conclusion, IDA is common in CD, and CD is frequently found in patients presenting with IDA. The treatment of IDA associated with CD is primarily a GFD and iron supplementation until the iron stores have been restored. This process can take as long as a year for the hemoglobin to normalize and 2 years for the iron stores to be replete.
Folate deficiency
Folic acid is an essential element of amino acid and nucleic acid metabolism and metabolic regulation.49 Adequate folic acid is required for normal hematopoiesis and development of the nervous system. Folic acid is primarily absorbed in the jejunum, and malabsorption is frequent in diseases of the small intestines.49,50 Deficiency of folic acid usually presents as macrocytic and megaloblastic anemia, but abnormalities of the other cell lines are common. Concomitant iron deficiency as can be seen in CD can result in atypical findings on the blood smear, and patients with deficiencies of folate and vitamin B12 may not present with the characteristic macrocytosis. Examination of the blood smear may reveal a dimorphic picture reflecting the effects of both deficiencies. Severe folic-acid deficiency can result in a decrease in both leukocytes and platelets and even manifest as severe pancytopenia. The diagnosis is usually made by measuring serum folate and red-cell folate levels. Serum folate is highly dependent on folate intake and is frequently increased in patients with deficiency of vitamin B12.51 Red-cell folate is not specific for folate deficiency, as it can be decreased in patients with vitamin B12 deficiency, but red-cell folate is less subject to transient changes secondary to variations in folate intake.51 Elevated serum homocysteine level can be helpful in diagnosing folate deficiency but its sensitivity is somewhat less for vitamin B12 deficiency.52,53
Previous studies have shown that many untreated patients with CD are folate deficient.13,54 Two small studies found that folate deficiency is a common finding in children but it does not usually result in anemia.55,56 More-recent studies have confirmed that folic-acid deficiency continues to be a frequent finding in subjects with newly diagnosed CD and even in adolescents and young adults with CD detected by screening.44,57,58 Folate deficiency has also been reported in association with DH.23,59 Homocysteine levels are commonly elevated in patients with CD at the time of diagnosis and may serve as a diagnostic clue.60 We recommend folate supplementation in conjunction with a GFD for treatment of these patients.
Vitamin B12 deficiency
Vitamin B12 is an essential cofactor and a coenzyme in multiple biochemical pathways, including the pathways of DNA and methionine synthesis. While the main site of vitamin B12 absorption is the distal ileum (where it is absorbed bound to intrinsic factor), a small proportion is also absorbed passively along the entire small bowel.61 Deficiency of vitamin B12 is common in CD and frequently results in anemia. Malabsorption of vitamin B12 resulting in anemia has also been described in patients with DH.20 The cause of the vitamin B12 deficiency in CD is not known but may include decreased gastric acid, bacterial overgrowth, autoimmune gastritis, decreased efficiency of mixing with transfer factors in the intestine, or perhaps subtle dysfunction of the distal small intestine.62,63
Recent studies suggested that 8% to 41% of previously untreated subjects with CD were deficient in vitamin B12.64,65 This is in accordance with an older study that reported 11% incidence of vitamin B12 deficiency in 50 consecutively diagnosed patients with CD.54 Vitamin B12 deficiency should be considered in all CD patients with hematologic and neurologic abnormalities. Measurements of vitamin B12 levels can be misleading and difficult to interpret, especially if the results fall within the lower range of normal or if there is a coexisting deficiency of folic acid.66 Elevated levels of serum methylmalonic acid (MMA) may enhance the diagnostic accuracy under these circumstances.67 Patients with vitamin B12 deficiency should receive therapy with parenteral vitamin B12. Even though studies have suggested that oral vitamin B12 may be as effective as parenteral vitamin B12, no such studies have been performed in patients with vitamin B12 deficiency secondary to CD.68
Deficiency of other micronutrients
The anemia seen in CD can also result from malabsorption of various micronutrients necessary for normal hematopoiesis. Copper deficiency has been described in adults and children with CD and may result in anemia and thrombocytopenia.69-72 We have recently diagnosed adult CD patients with symptomatic copper deficiency (T.R.H. and J.A.M., unpublished data, October 2006). Deficiencies in vitamin B6, pantothenic acid, and riboflavin have also been suggested as etiologic factors in patients with CD but recent data are lacking.13
Thrombocytopenia and thrombocytosis
Thrombocytopenia has rarely been reported in patients with CD and may be autoimmune in nature.72-77 Thrombocytopenia associated with CD has been reported in association with keratoconjunctivitis and choroidopathy, suggesting an autoimmune pathophysiology.73,74 The best therapy for thrombocytopenia in association with CD is uncertain, given the rarity of the problem, but a GFD may result in normalization of the platelet count in some cases.72
Thrombocytosis in association with CD appears to be more common than thrombocytopenia, occurring in up to 60% of patients.78-81 The exact etiology of the thrombocytosis is unknown but it may be secondary to inflammatory mediators or, in some cases, secondary to iron-deficiency anemia or functional hyposplenia.82 The thrombocytosis may resolve after institution of a GFD.79,80
Leukopenia/neutropenia
Abnormally low white-blood count has been reported in a few children with CD.72 These findings appear to be rare, and deficiencies of both folate and copper have been implicated as possible etiology for the leukopenia.69,70,83 The data on treatment of these patients are extremely limited but we recommend initiating a GFD and supplementing these patients' diets with oral copper sulfate if there is evidence of copper deficiency.
Venous and arterial thromboembolism
Venous thrombosis has been reported in CD and may be the presenting feature. Hyperhomocysteinemia is a frequent finding in CD and may be related to an increased tendency to form clots.60 Increased levels of thrombin-activatable fibrinolysis inhibitor (TAFI) have recently been reported in patients with inflammatory bowel disease and CD.84 Elevated levels of TAFI have been shown to be a risk factor for venous thromboembolism.85 Decreased levels of the K vitamin–dependent anticoagulant proteins, protein S and C, has recently been suggested as a causative factor in thrombosis associated with CD.86 Not all studies support the link between CD and hypercoagulability, however.87 The clinical spectrum of thromboembolism observed in patients with CD is variable, but most cases appear to involve the venous circulation.88-90 Only a few case reports have included patients with thrombosis on the arterial side of the circulation, and in those cases the role of CD in the mechanism of the thrombosis was uncertain.91-93
Coagulopathy
CD can be associated with abnormalities in coagulation factors resulting in an abnormal bleeding tendency. Malabsorption of vitamin K is common in chronic gastrointestinal disorders. A decrease in K vitamin–dependent coagulation factors results in prolongation of coagulation assays such as the prothrombin time (PT), international normalized ratio (INR), and the activated partial thromboplastin time (aPTT).94,95 A recent study found that 18.5% of untreated CD patients had prolongation of PT and these patients were also more likely to present with anemia and abnormal iron proteins.96 Symptomatic patients were also more likely to present with a prolonged PT. Patients with CD occasionally present with hemorrhagic diathesis as their first symptom. The resulting hemorrhage can be minimal to severe.97-99 Therapy is initially parenteral vitamin K, but occasionally plasma products may be needed in bleeding patients. Malabsorption of vitamin K is very uncommon in CD patients who do not have ongoing malabsorption of other nutrients.96 The treatment primarily consists of initiating a GFD and correcting the vitamin K deficiency.
Splenic dysfunction
Splenic atrophy in patients suffering from malabsorption secondary to nontropical sprue was first described in 1923.100 Multiple cases of splenic atrophy in association with malabsorption and CD or DH were subsequently published.101,102 Unsuspected CD may be found when patients with evidence of hyposplenism are investigated for the condition.103 Splenic hypofunction can be demonstrated using scintigraphy and measurements of the clearance of labeled heat-damaged red cells.101 A commonly used method of assessing splenic function in patients with CD is to count “pitted” erythrocytes by interference contrast microscopy.104 This method has the advantage of being simple to perform but unfortunately it is labor intensive and many laboratories do not routinely offer this test. A pitted-erythrocyte count of more than 2% to 4% is indicative of hyposplenism.104-106 The presence of Howell-Jolly bodies, acanthocytes, and target cells is suggestive of hyposplenism but may not be apparent in patients with milder forms of hyposplenism (Figure 2).107,108
Blood smear showing characteristic findings of hyposplenism such as Howell-Jolly bodies, acanthocytes, and target cells. Image was observed using an Olympus Provis AX70 microscope equipped with an Olympus PlanApo 60 ×/1.40 numerical aperture oil objective (Olympus, Tokyo, Japan). Resolve high-viscosity immersion oil was used as imaging medium, and cells were stained with Wright-Giemsa. Image was acquired using a Nikon DXM 1200 digital camera and Nikon ACT-1 software version 2.62 (Nikon, Melville, NY).
Blood smear showing characteristic findings of hyposplenism such as Howell-Jolly bodies, acanthocytes, and target cells. Image was observed using an Olympus Provis AX70 microscope equipped with an Olympus PlanApo 60 ×/1.40 numerical aperture oil objective (Olympus, Tokyo, Japan). Resolve high-viscosity immersion oil was used as imaging medium, and cells were stained with Wright-Giemsa. Image was acquired using a Nikon DXM 1200 digital camera and Nikon ACT-1 software version 2.62 (Nikon, Melville, NY).
The prevalence of hyposplenism in patients with CD is not well known. Croese et al78 found evidence of hyposplenism in 15 (21%) of 70 of their patients with CD. Other investigators have reported an incidence of 30% to 60% in adults with CD.108-111 Hyposplenism appears to be more common when CD coexists with other autoimmune disorders such as insulin-dependent diabetes mellitus, autoimmune thyroiditis, and connective-tissue disorders and when CD is complicated by lymphoma, refractory CD, or ulcerative jejunitis (59%-80%) than uncomplicated CD (19%), according to a recent report from Italy (Di Sabatino et al112 ). O'Grady et al113 studied 177 patients with CD using pitted-erythrocyte counts. Seventy-six percent were found to have hyposplenism as manifested by the presence of pitted erythrocytes. Higher counts were found in older patients and in patients who had more-pronounced morphologic findings on a small-bowel biopsy. Adherence to a GFD was associated with a decrease in pitted-erythrocyte counts, suggesting that the hyposplenism may be reversible in some patients who maintain such a diet. Other investigations have not supported this and have, on the contrary, suggested that splenic hypofunction may be irreversible in adult patients with CD.114 Hyposplenism appears to be much less common in children with CD, as reported by Corazza et al.115 In their report of 37 children with CD, none were found to have the elevated pitted-erythrocyte count suggestive of hyposplenism. Various autoantibodies including antinuclear antibodies, anti–smooth-muscle antibodies, and antimitochondrial antibodies have been found in patients with CD and hyposplenism.116
The risks associated with hyposplenism in patients with CD are unknown. Infectious complications appear to be uncommon, given the reported frequency of hyposplenism. Several case reports of severe and even fatal bacterial infections in such patients have, however, been published.117-119 Cavitating lesions in mesenteric lymph nodes and the lungs have also been reported in patients with CD and hyposplenism and can be associated with significant mortality, presumably due to an overwhelming infection.120-123 The etiology of these cavitating lesions is unknown but some authors have suggested that immune complexes result in endothelial damage leading to intranodal hemorrhagic necrosis.123,124
It is not known whether immunizations against encapsulated bacteria prevent infectious complications in CD patients with splenic dysfunction, and no firm conclusions can be drawn regarding routine immunizations in these patients. It seems reasonable to evaluate patients with CD for evidence of hyposplenism as manifested by characteristic blood-smear findings such as Howell-Jolly bodies, acanthocytes, and target cells. The blood-smear examination lacks sensitivity for detecting hyposplenism but can easily be performed in most laboratories. Patients with signs of hyposplenism should be treated in a similar fashion as patients who are asplenic because of other reasons such as elective or emergency splenectomy. Immunization against the encapsulated bacteria Streptococcus pneumoniae, Haemophilus influenzae type b, and Neisseria meningitidis is recommended.125-127 Younger patients should be considered for prophylactic therapy with antibiotics and all patients should receive education on the infectious complications associated with hyposplenism.125-127 A small study has suggested that the antibody response to the polyvalent pneumococcal vaccine is intact in patients with CD.128
IgA deficiency
CD and selective IgA deficiency are associated more often than expected by chance alone. Approximately 2% to 3% of CD patients have IgA deficiency, and up to 8% of IgA-deficient individuals may have CD.12,129,130 Partial IgA deficiency has recently been described in 2 patients with DH.131 Patients with IgA deficiency have up to a 10-fold higher risk of suffering from CD, and the prevalence of IgA deficiency among CD patients is 10- to 16-fold what is to be expected in the general population.129,132 The importance of the association is 2-fold. Firstly, IgA-deficient individuals are prone to other enteric conditions such as inflammatory bowel disease or chronic parasite infections, especially giardiasis, which could mimic CD. Secondly, patients with IgA deficiency are at risk of developing anaphylactic transfusion reactions that may be life threatening if the recipient has anti-IgA antibodies.133
Lymphoma
The association of CD and intestinal lymphoma is well known.7,134 This association was first described in 1937 by Fairley and Mackie.174 Initially it was thought that the enteropathy and malabsorption that occurred was secondary to the lymphoma itself, a concept that persisted for many decades until it became apparent that the CD preceded the lymphoma.134 Later reports suggested that lymphoma involving the GI tract was relatively common and possibly a major cause of death in patients with CD.135-137 Multiple studies now support the association of CD and lymphomas.138-149 The association between CD and intestinal T-cell non-Hodgkin lymphoma (NHL), called enteropathy-associated T-cell lymphoma (EATL), appears to be particularly strong but these aggressive lymphomas are rare. The current World Health Organization (WHO) classification of lymphomas has recommended the term enteropathy-type T-cell lymphoma (ETL).7 In this article we use the terms ETL and EATL synonymously.
ETLs are rare lymphomas accounting for less than 1% of all NHL.150 ETL frequently presents as multifocal lymphoma with ulcerative lesions and commonly results in bowel perforation or other abdominal emergencies.151,152 The malignant cells of ETL appear to arise as clonal proliferations of phenotypically abnormal intraepithelial lymphocytes (IELs).153,154 Loss of CD8 expression by IELs is characteristic for early ETL. Patients with refractory CD have been found to harbor clonal IELs that share a similar immunophenotype to ETL, but there can be substantial heterogeneity in the phenotype of IELs.154-156 The IELs seen in refractory CD have been shown to express cytosolic CD3 (cCD3) and to be monoclonal when T-cell receptor gene-rearrangement studies are performed.157,158 Loss of CD8 expression by IELs is characteristic for early ETL.156,157 Interleukin-15 appears to be an important signaling molecule in driving the expansion of the IELs.159 The monoclonal IELs seem to be neoplastic, and accumulation of these phenotypically aberrant IELs appears to be the first step in the pathogenesis of ETL.154 The etiology of this increase in monoclonal IELs is unknown but may be secondary to chromosomal gains or mutations of tumor-suppressor genes.154 ETL cells typically express CD3, CD7, and CD103; they may express CD30 but are usually negative for CD4, CD5, and CD8.154 Sometimes the ETL cells lack CD3 expression.160 Immunostaining for CD3, CD8, and CD4 may be helpful for initial screening, but molecular-clonality analysis is required for confirmation in the cases suspected to have early ETL.
The risk of developing an NHL as a complication of CD is not fully known, but recent epidemiologic studies suggest a relative risk ranging from 2.1 to 6.6.144,145,148,149,161-164 The risk of contracting lymphoma in the setting of DH appears to be increased to a similar degree.145,162,165 Other studies have indicated that there may be a much higher risk, ranging from a 15-fold up to 100-fold increase.136,138-140,166 Ascertainment bias may account for some of the difference noted in these studies. There is a strong relationship between CD and ETL. One study showed that the odds ratio (OR) of being diagnosed with ETL was 19.2 among patients with CD.144 A more recent Swedish study (Smedby et al148 ) showed the standardized incidence ratio (SIR) for ETL to be 51. Even though the relative risk of developing ETL is most significantly increased in CD patients, non-ETLs, including B-cell NHL and extraintestinal T-cell NHL, are more common in aggregate than ETL in these patients.148,149,163
Several recent studies on the relationship between NHL and CD deserve special mention. Catassi et al144 reported the results of a case-control study attempting to quantify the risk of NHL in patients with CD. The study included 653 patients with NHL. Six of the patients had CD: 3 had lymphoma of B-cell origin and 3 had lymphoma of T-cell origin. The control group in this series consisted of 5720 adults participating in 2 mass CD-screening studies. The researchers were able to calculate the age- and sex-adjusted OR for developing lymphoma in patients with CD. The OR for developing NHL at any primary site was 3.1. The ORs for primary gut lymphoma and T-cell lymphoma were substantially higher, at 16.9 and 19.2, respectively.144 These calculations were based on very low numbers of lymphoma cases, however.
Using a different approach, Askling et al145 observed an SIR of 5.9 for developing a lymphoma among CD patients. Their study evaluated 11 019 hospitalized CD patients identified through the national Swedish hospital inpatient registry. Forty-four cases of lymphoma were diagnosed in these patients, using a linkage between the inpatient registry and the national cancer and death registries. Patients with incident cancers occurring within 12 months from hospital dismissal were excluded from the analysis. Patients hospitalized at a younger age had a lower risk of being diagnosed with lymphoma in the subsequent years than the patients hospitalized at an older age.145 The relative risk also decreased over calendar time, perhaps suggesting that early institution of a GFD may decrease the risk of contracting lymphoma secondary to CD. Given the fact that these patients were hospitalized, they may not represent the group of CD patients with milder forms of the disease. A recently published 30-year population-based study from Finland (Viljamaa et al162 ) followed 1147 patients diagnosed with CD or DH at a single medical center over 17 245 person-years. This study reported an SIR of 3.2 and 6.0 for developing NHL in patients diagnosed with CD or DH, respectively. The SIR was slightly lower than in other reports, and the study provided further support to the theory that compliance with a GFD protects against the development of lymphoma in patients with CD.
A large population-based case-control study undertaken in both Denmark and Sweden (Smedby et al161 ) assessed the risk of NHL in patients with a variety of autoimmune disorders, including CD. Participants including 3055 patients with NHL identified through a national hospital and tumor registries and 3187 matched controls were surveyed regarding a history of autoimmune disorders. Nineteen patients with NHL and 9 controls reported a previous diagnosis of CD. CD was associated with a doubled risk of NHL with an OR of 2.1. The OR for diffuse large B-cell lymphoma (DLBCL) was 2.8 in contrast to an OR of 17 for T-cell lymphoma. Ten lymphomas were extranodal, including 5 involving the GI tract. The OR for GI NHL was estimated to be 12 in comparison with an OR of 1.7 for non-GI NHL. Another study published earlier this year reports a similar magnitude of risk for CD patients contracting NHL.163 This European, prospective, multicenter case-control study identified 1446 patients with newly diagnosed NHL who were willing to be screened for CD by serology and subsequently be evaluated with a small-bowel biopsy. Thirteen patients had previously been diagnosed with CD and an additional 4 patients were found to have CD after the diagnosis of NHL was made. After adjusting for age and sex, the OR for contracting NHL in the setting of CD was 2.6. Of the 17 patients, 8 had ETL and another 8 had DLBCL. The OR for small-bowel NHL and ETL were 11.8 and 28, respectively. Table 3 summarizes the findings of several recent studies evaluating the increased risk of being diagnosed with a lymphoma in patients with CD.
Multiple studies suggest that there may be a reduction of risk with long-term adherence to a GFD.138,139,142,143,145,146,162 A GFD may also reduce the risk in patients with DH.167,168 The benefit of a GFD may be slow in accruing in those who are diagnosed later in life and, in at least 1 study, the risk of NHL seemed to persist.149
The risk of being diagnosed with an NHL is thus clearly increased in patients with CD but the risk appears less than earlier reports suggested. The highest increase in risk relates to T-cell intestinal lymphomas (ETLs), but these uncommon lymphomas constitute a minority of all CD-related lymphomas. The risk of acquiring a B-cell lymphoma of the gut or extraintestinal T-cell lymphoma is also increased in CD patients but less than with ETL, and collectively the non-ETLs account for the majority of CD-associated lymphomas.
Therapy for CD-associated lymphoma is not different from the therapy used in similar lymphomas in patients without CD. However, the presence of CD may raise issues of malnutrition, an increased risk of infection due to concomitant hyposplenism, and increased likelihood of diarrhea or other consequences of CD. Combination chemotherapy is most frequently used, and the choice of regimen depends on the lineage of the lymphoma. B-cell lymphomas are usually treated with combinations such as CHOP (cyclophosphamide, doxorubicin, vincristine, and prednisone) with rituximab. T-cell–derived lymphomas have been more challenging to treat. Case series of patients with NHL associated with CD have yielded variable results but suggested that selected patients may enjoy prolonged survival.148,151,152,169,170 One study suggested that the prognosis of stage IV NHL was worse in patients with CD compared with those without CD.169
Therapy of ETL is currently unsatisfactory, with a 5-year survival ranging from 11% to 20% in 2 studies and a 2-year survival of 28% according to another study.151,152,171 Survival of patients with T-cell intestinal lymphoma appears to be inferior to the survival of patients with intestinal B-cell lymphoma and patients with other types of peripheral T-cell lymphomas.171,172 The chemotherapy regimens that have been used for treatment of CD-associated T-cell lymphomas are very heterogeneous, mostly involving CHOP or similar anthracycline-based regimens.151 A recent study evaluated the efficacy of CHOP with the addition of etoposide (CHOEP) and reported a disappointingly low response rate and significant toxicities.173
Conclusion
Celiac disease is a frequent cause of hematologic disorders. Anemia and hyposplenism may be the most common hematologic complications. The anemia is most commonly secondary to iron deficiency but deficiencies of folate, vitamin B12, and other micronutrients have been implicated as well. It seems reasonable to obtain a small-bowel biopsy in all patients with iron-deficiency anemia undergoing an upper endoscopy, regardless of the endoscopic findings. The hyposplenism complicating CD is rarely associated with serious infectious complications but it is appropriate to immunize patients against encapsulated bacteria if there is evidence of splenic hypofunction. The risk of lymphoma associated with CD has been overestimated in the past but current estimates suggest that the relative risk is between 3 and 6. The risk is highest for T-cell lymphomas of the gastrointestinal tract (EATL) and other non-Hodgkin lymphomas of the GI tract.
Conflict-of-interest disclosure: the authors declare no competing financial interests.
Contribution: J.A.M. provided the concept; T.R.H., M.R.L., and J.A.M. designed the review; T.R.H. wrote the first draft; and T.R.H., M.R.L., and J.A.M. edited the revision and gave final approval.
Acknowledgments
Thanks to David J. Inwards, MD, and Ahmet Dogan, MD, PhD, for reviewing the section on lymphoma.
This work was supported by National Institutes of Health (NIH) grants DK 71003 and DK 57892 (J.A.M.).